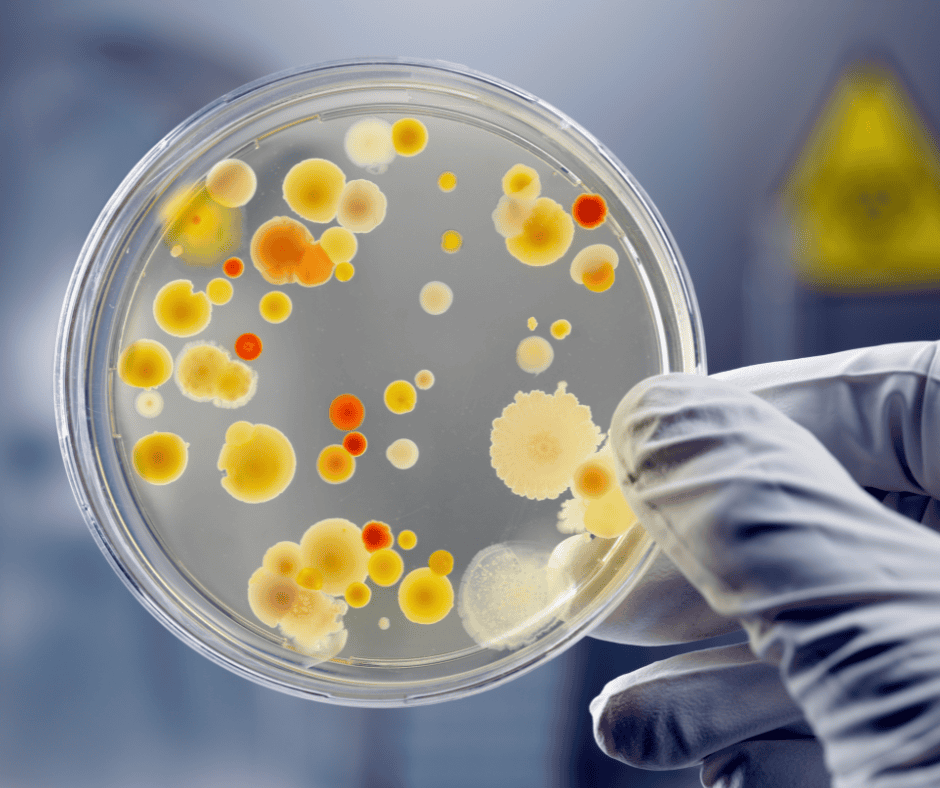

Special and Incentive Pays
There are many incentive and special pays that are paid to members serving in particular specialties or due to the hazardous nature, location, or special skills necessary to perform these jobs. This list may not be all inclusive but they can all be found in the DODFMR Volume 7.

Career Sea Pay
Career Sea Pay (CSP) may be entitled to officers, warrant officers, and enlisted members when there is more than the normal rigors of sea duty assignments. CSP-P is special pay that is in addition to CSP and is paid for unusually long periods of continuous sea duty. When a member has served more than 36 consecutive months of sea duty, they will be entitled to receive CSP-P for every month beyond the initial 36 months for every additional month they serve on sea duty.
Your actual CSP depends on rank and number of years served at sea. The amount is taxed, unless you are serving in a designated tax-free zone.
The DODFMR Volume 7A, Chapter 18 regulates the entitlement and conditions to CSP and CSP-P.

Submarine Duty Pay
Submarine Duty Pay is an Incentive pay for operational submarine duty, which is designed to recognize the arduous nature of submarine duty assignments. The monthly rate payable to officers ranges from $255 to $950, warrant officers from $320 to $475, and enlisted members may receive between $85 to $600.
DODFMR Volume 7A, Chapter 23 provides guidance for Submarine Pay.

Nuclear-Qualified Officers Special Pays
In order to train and retain nuclear-qualified officers, the Navy is authorized different special pays including the Nuclear Officer Accession Bonus, Nuclear Career Accession Bonus,
Nuclear Officer Continuation Bonus (COBO), and Nuclear Career Annual Incentive Pay (AIP).
The DODFMR Volume 7A, Chapter 3 Paragraph 7 covers the entitlements, requirements, and amounts payable.

Aviation Incentive Pays
The DoD offers four primary types of aviation incentive pay when military duties involve aerial flight operations. The DODFMR Volume 7 Chapter 20 and and DODFMR Volume 7 Chapter 22 cover the eligibility, definitions, restrictions, and requirements to receive any aviation incentive pay.
Aviation Career Incentive Pay (AvIP)
The Secretaries of the Military Departments may offer AvIP to increase their respective Department’s ability to retain officers in a military aviation career and support the recruiting and retention of individuals with military aeronautical ratings or designations. Officers must achieve a minimum number of hours of operational or proficiency flying duty to maintain eligibility. The various services manage the amounts, currently payable at a rate from $125 to $1,000 per month.
Critical Skill Incentive Pay
CSIP may be paid in lieu of Hazardous Duty Incentive Pay (HDIP) for enlisted crew members only for holding an occupational specialty or rating designated as critical by the Secretary of the Military Department concerned. The current CSIP amounts range from $255 to $600 per month.

Aviation Bonus Pay (AvB)
The Secretaries of the Military Departments may offer an AvB of up to $35,000 per year to increase their respective Department’s ability to attract and retain officers in a military aviation career on a selective basis when there is a shortage or a projected shortage of Regular or Reserve Component (RC) officers qualified in critical aviation specialties. The DODFMR Volume 7A, Chapter 20 governs eligibility, amounts payable, and terms and conditions for AvB.
Flying Duty Hazardous Duty Incentive Pay (HDIP)
To be eligible for Flying Duty HDIP, a Service member must be required by competent orders to participate frequently and regularly in sustained, powered, controlled aerial flights, and generally must complete 4 hours, or 2 hours for reserve component (RC) service members of aerial flights each month. Officers, including aviation cadets entitled to AvIP under section 3.0, are not entitled to payments under this section for the same period of service. Enlisted members receiving CSIP under section 5.0 are not entitled to payments under this section for the same period of service.
Monthly rates for officers are $150 to $250 and enlisted members are eligible for payments of $150 to $240. See DODFMR Volume 7A, Chapter 22 Paragraph 2 for all details.

Hazardous Duty Incentive Pay Other than Aerial Flights
The military is a dangerous business and some specialties require members to perform duty that is particularly hazardous and pays incentives to members to acquire and maintain proficiency in certain skills. The DODFMR Volume 7A, Chapter 24 governs these entitlements.

Parachute Duty
Qualified members, or members undergoing training for such qualification, with orders to jump from a flying aircraft, and that meet performance requirements are entitled to Parachute Duty Pay. The monthly rate payable is $150 per month for static line jumping, and $225 per month for freefall or High Altitude Low Opening (HALO) jumps.
DODFMR Volume 7A, Chapter 24 - see Paragraph 3.

Flight Deck Duty
The Secretary concerned may offer Flight Deck HDIP (FDHIP) to those on orders who perform flight deck hazardous duty. These members must be assigned to a duty station where aircraft are launched and recovered during flight operations. These members must participate in flight operations, including those from an aircraft carrier or other ship where these operations occur. The current rate for flight deck operations is $150 per month.
DODFMR Volume 7A, Chapter 24 - see Paragraph 4

Demolition Duty
A member entitled to basic pay, who is required by competent orders to perform duty involving the demolition of explosives, as prescribed by their branch regulations. This must be a primary duty or training for that duty, and the member is entitled to HDIP under the conditions stated in this section. Demolition duty pay is $150 per month.
DODFMR Volume 7A, Chapter 24 - see Paragraph 5
Experimental Stress Duty
A member on active duty orders where they perform experimental stress duty is entitled to HDIP of $150 per month when participating in any of the following duties:
- Human Acceleration or Deceleration
- Thermal Stress
- Low-Pressure Chamber
- High-Pressure Chamber
DODFMR Volume 7A, Chapter 24 - see Paragraph 6

Toxic Fuels or Propellants Duty
A member is eligible for HDIP when they are involved in servicing missiles or aircraft that contain highly toxic propellants or fuels for their primary duty. This may also be given to members who test missile systems, including portions of those systems, or aircraft that use highly toxic fuels as part of a primary duty assignment. This HDIP of $150 is payable monthly when meeting the criteria.
DODFMR Volume 7A, Chapter 24 - see Paragraph 7
Toxic Pesticides Duty
A member is eligible for HDIP of $150 monthly for duty involving frequent and regular exposure to highly toxic pesticides when the member is assigned orders for pest control and/or pest management, entomology, or preventative medicine functions for a period of 30 or more consecutive days.
DODFMR Volume 7A, Chapter 24 - see Paragraph 8
Dangerous Viruses or Bacteria Lab Duty
HDIP for laboratory duty involving dangerous viruses or bacteria is $150 per month. Service members who meet the eligibility criteria, but who do not participate in a full calendar month of laboratory duty utilizing live viruses or bacteria will receive a prorated HDIP payment.
DODFMR Volume 7A, Chapter 24 - see Paragraph 9
Chemical Munitions Duty
HDIP for handling of chemical munitions is $150 per month (see the HDIP Rates table for the most current rate). Service members who meet the eligibility criteria, but who do not participate in a full calendar month of duty handling chemical weapons will receive a prorated HDIP payment.
DODFMR Volume 7A, Chapter 24 - see Paragraph 10
Maritime Visit, Board, Search, and Seizure (VBSS) Duty
The Secretary concerned may offer an HDIP of $150 monthly to service members with orders for VBSS billets duty. These members will be aboard vessels that support the maritime interdiction operations where they require regular, or frequent, participation in VBSS operations. Service members are eligible for HDIP for VBSS operations and may be paid a full month’s VBSS HDIP during any calendar month in which the Service member serves in such a billet and conducts the minimum number of boarding operations.
DODFMR Volume 7A, Chapter 24 - see Paragraph 11
Polar Region Flight Operations Duty
A member is eligible for HDIP of $150 per month when there is use of any ski-equipped aircraft located in Antarctica or on the Arctic Ice-Pack for their assigned duty.
DODFMR Volume 7A, Chapter 24 - see Paragraph 12
Weapons of Mass Destruction Civil Support (WMDCS) Team
HDIP for Reserve Component Service members assigned to a WMDCS team is $150 per month. Service members who meet the eligibility criteria, but who do not participate in a full calendar month as a WMDCS team member, will receive a prorated HDIP payment.
DODFMR Volume 7A, Chapter 24 - see Paragraph13

Diving Pay
The DODFMR Volume 7A, Chapter 11 prescribes the entitlement, requirements, and conditions for the special pay known as Diving Pay. The rate payable is dependent on being assigned to diving duty, whether the member is officer or enlisted, proficiency level, and branch of service to which the member is assigned. Rates payable are up to $240 per month for officers and up to $340 dollars a month for enlisted.
Special Warfare Skill Incentive Pay (SWSIP)
The Air Force may pay a monthly skill incentive pay not to exceed $615 to Airmen qualified and serving as an Air Force Special Warfare (AFSPECWAR) Airmen. AFSPECWAR Airmen conduct operations in the ground domain in contested, denied, operationally limited, and permissive environments under severe environmental conditions. Details including eligible Air Force Specialty Codes are listed in DODFMR Volume 7A, Chapter 24 - see Paragraph 15.
Naval Special Warfare (NSW) Skill Incentive (SKIP)
The Navy may pay a monthly skill incentive pay not to exceed $715 per month to Service members qualified and serving as NSW Operators performing clandestine paradrop, maritime, and land-based special operations in austere conditions in order to provide to the United States and its allies tailored capabilities. Specific information including eligible Navy enlisted classifications (NECs) and officer designator codes for the entitlement are covered in DODFMR Volume 7A, Chapter 24 - see Paragraph 16.

Hostile Fire (HFP) and Imminent Danger Pay (IDP)
These special pays are available for any months where the member could be subject to hostile fire or may be in imminent danger for their assigned duty. They must meet the qualifying criteria in the DODFMR Volume 7A, Chapter 10. A member is not authorized to receive concurrent payments for hostile fire and imminent danger duty.
HFP has a rate of $225 per month when, as certified by the appropriate commander, a member is subjected to hostile fire, explosion of a hostile mines, or other hostile action. IDP is paid on a daily prorated basis when the member is in a designated IDP area on official duty, but it is not to exceed $225 per month, IDP may be paid to where is threat of physical harm or imminent danger to the service member. This could be due to civil war, terrorism, civil insurrection, or wartime conditions in a designated foreign area. Table 10 within this chapter lists the areas subject to IDP. You may also see the list at Defense Finance and Accounting Service IDP Areas.
Combat Zone Tax Exclusion (CZTE) - Income Tax Exclusion When Serving in a Combat Zone (CZ) or Qualified Hazardous Duty Area (QHDA)
All compensation of an enlisted member or warrant officer received for a month in which the enlisted member or warrant officer performed active duty in a CZ or Qualified Hazardous Duty Area (QHDA) qualifies for the CZTE. For commissioned officers, the CZTE is limited to the amount of the senior enlisted member’s basic pay added to the HDP or IDP that is actually given to the officer during the duty month. See DODFMR Volume 7A, Chapter 44 for additional details and tables designating CZ and QHDA locations.

Military Pay & Entitlements Series
1. Introduction
2. Basic Pay
3. Basic Allowance for Subsistence (BAS) – Food Allowance
4. Basic Allowance for Quarters (BAH) – Housing Allowance
5. Common Deductions
6. How to Read Your Leave and Earnings Statement (LES)
7. Uniform and Clothing Allowances
8. Cost of Living Allowance (COLA)
9. Special and Incentive Pays
10. Additional Special and Incentive Pays
11. Overseas or Station Allowance
12. PCS and Travel
13. Special Situations
Explore More with My Military Lifestyle and Finances!